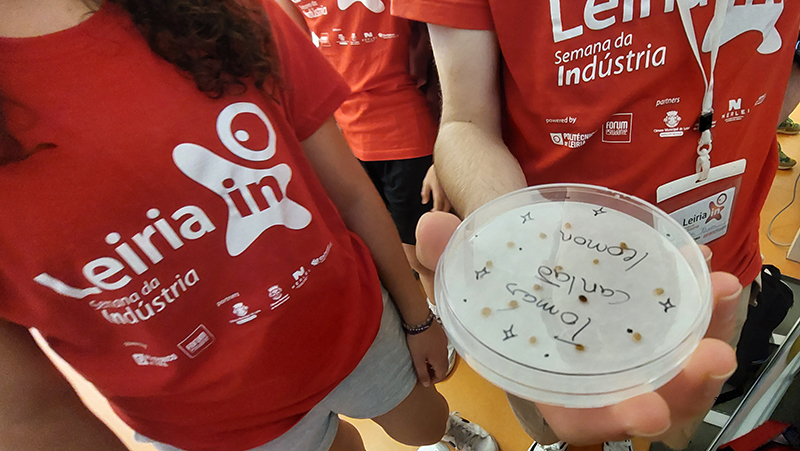

A manhã começou com atividades no CETEMARES, o centro de investigação científica, de desenvolvimento tecnológico e de inovação em ecossistemas aquáticos do Politécnico de Leiria, instalado em Peniche, onde se encontra a Escola Superior de Turismo e Tecnologia do Mar do IPL.
Depois de conhecer alguns dos projetos em desenvolvimento neste centro, os participantes puderam meter mãos à obra e experimentarem, eles mesmo, o que os investigadores fazem diariamente.

Divididos por quatro estações, as equipas, acompanhadas por professores investigadores, puderam testar o comportamento dos ouriços do mar, quando expostos a ambientes com luz de diferentes cores e também com diferentes algas, tudo com o propósito de perceber quais os ambientes artificiais mais propícios a criação desta espécie, com o objetivo de desenvolver a aquicultura dos ouriços, que é uma iguaria cada vez mais apreciada. Ao fazer a sua cultura em ambiente controlado, não só se certifica a qualidade, como também não se põe em perigo a espécie que vive na natureza.

Noutro posto, os participantes avaliaram a frescura do carapau, com uma série de análises sensoriais, como o cheiro e o tato, mas também observando cor e forma dos olhos ou das brânquias. Com esta análise e a pontuação dada a cada aspeto, de acordo com os parâmetros definidos, qualquer consumidor de peixe pode avaliar a frescura do peixe que compra.

No laboratório de química, observou-se a reação do pigmento de uma planta, quando exposto a reagentes como a lixívia e cloro entre outros. Foi possível ver que as plantas testadas geram uma larga gama de cores quando expostas a diferentes reagentes.

Por último, os participantes puderam testar a ação do chorão da praia em sementes de tomate, com o objetivo de usar aquela que é uma espécie invasora nas dunas e encostas das nossas praias no combate às pragas da fruta, nomeadamente a pera rocha e a maçã de Alcobaça.
Para a tarde ficou reservada uma ida à praia, aproveitando a presença em Peniche para aproveitar o areal do Molhe Leste. Foi um momento para relaxar, apanhar sol e tomar banho, pois o dia estava convidativo.
O quinto e último dia deste Leiria-In vai misturar automóveis, robots, saúde e escorregas. Amanhã ficarão a saber tudo!